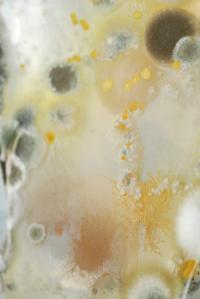
Untitled | DER GREIF

Subscribe to the Newsletter

Metal seed, industrial shell. Plants were observed, measured, and grown behind glass.
Regulated. Patented, owned. Seeds modified in such a way that, after a single use, they are unable to reproduce.
At the inception of photography, the cyanotype photographic process was used for a better understanding of plants by archiving their direct images. Algae, ferns in deep blue sea imprinted, revealing their fragile structures. Later the process was used for the creation and planning of larger man-made constructions, providing literal blueprints for the anthropocentric structures we live in.
The interdisciplinary project Unworlded, Bewildered aims to treat the image as an ecosystem. As I critically reflect on the role of image production in the capitalization of biodiversity, through evolving experiments, I dissect how this role could be reversed by acting counter to contemporary image culture: challenging permanence and reproducibility with temporality, ownership with kinship, and embracing mutability and mutualism as central ways of ecological being.
In the ecosystem of an image, where light, time, and sensitive material interact in their physical environment, I introduce microorganisms to the cyanotype photographic process, making images that go beyond the representation of the environment to become environments, or ecosystems, themselves. Light feeds the emulsion; emulsion feeds bacteria, they generate energy and spread over time. In repurposed greenhouse glass formed vessels, these elements co-exist, affect each other, and grow.
The work consists of nine sculptural glass objects containing a temporary bio-chemical process, photographic prints, and a publication dummy.
Ieva Maslinskaitė is part of »Guest Room: Michael Famighetti«.
Check out her Artist Feature In a Pupa.